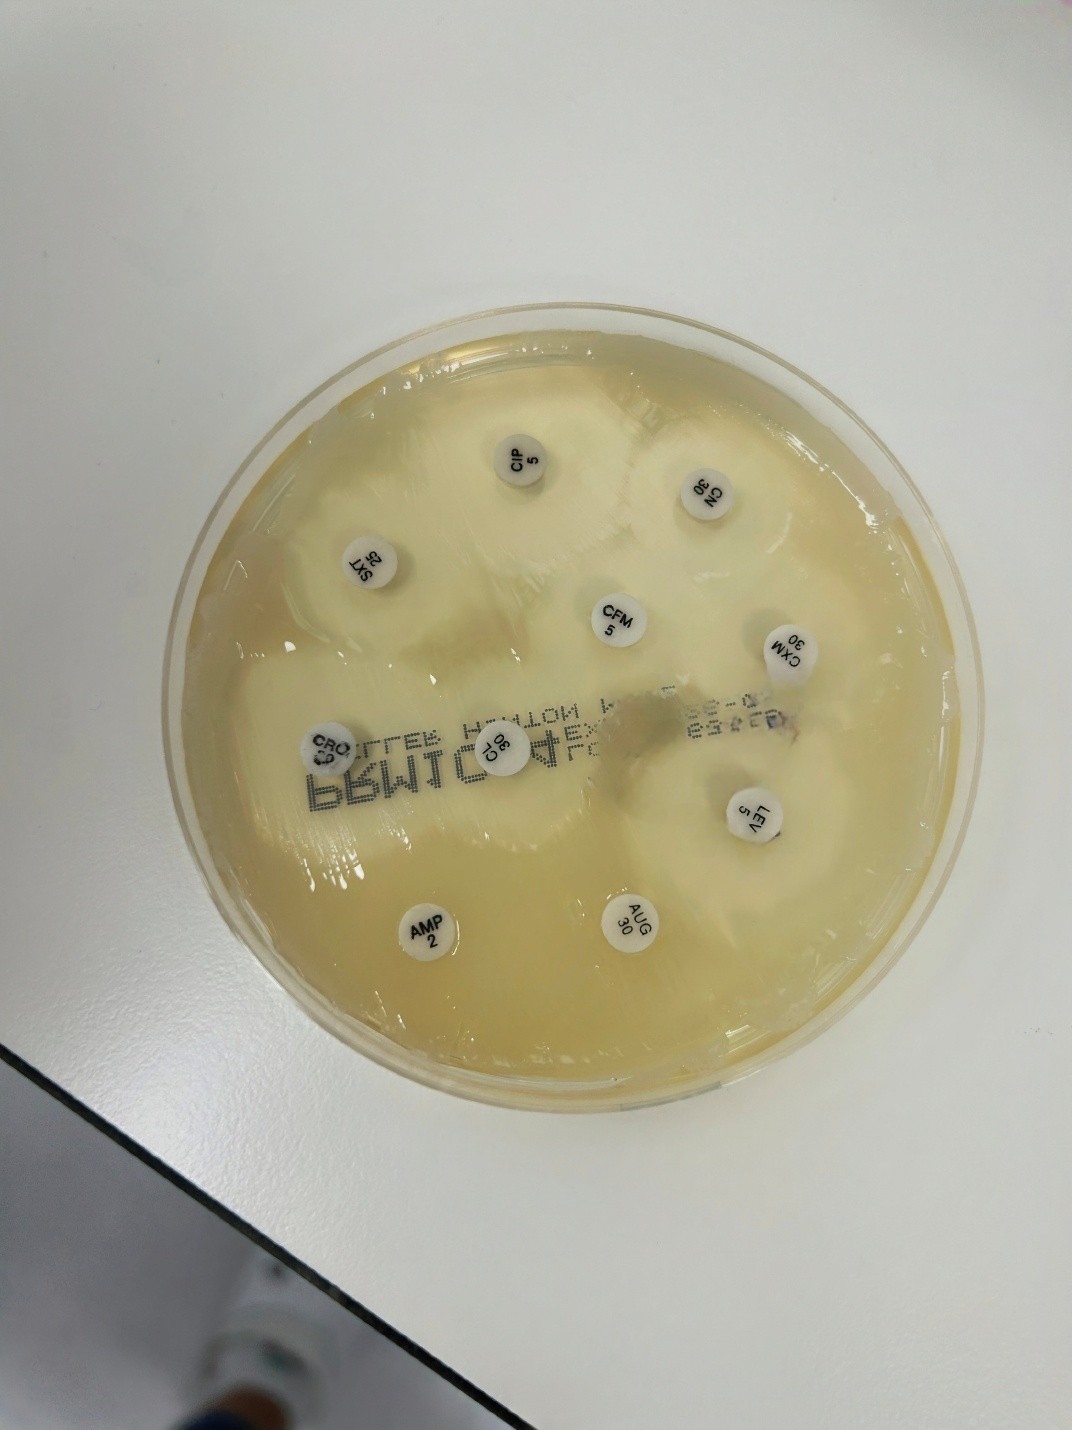
antibiogram

Imate li i vi ladicu s ostacima antibiotika? Evo zašto je opasno posegnuti za njom

Većina nas u kući čuva „ostatke“ prošlih terapija. Iako se čini kao brza pomoć, uzimanje antibiotika na svoju ruku maskira stvarne infekcije i otežava laboratorijsku dijagnostiku. Saznajte što mikrobiološki nalazi govore o vašim navikama.
Antibiotik „iz ladice“ i put do laboratorija: što nalazi otkrivaju o našim navikama
Kućna ladica s ostacima antibiotika nerijetko je prva stanica liječenja, čak i prije nego što pomislimo otići liječniku. Javi se bol u grlu ili poraste temperatura, a rješenje tražimo među tabletama preostalima od prošle terapije. Ovakva praksa je česta, razumljiva, ali i problematična. Iako nekoliko tableta može privremeno ublažiti simptome, one istodobno „maskiraju“ stvarnu sliku infekcije.
Iz perspektive mikrobiološkog laboratorija, to vidimo gotovo svakodnevno. Uzorci dolaze nakon započete terapije, nalazi budu nejasni, ponekad i negativni, a liječenje se dodatno komplicira. Ovakvi slučajevi nisu rijetki; zapravo se događaju gotovo redovito, posebno tijekom sezone respiratornih infekcija. Posljedica je da se terapija često produžuje, mijenja ili započinje „naslijepo“, umjesto da se od početka vodi na temelju jasnog i pouzdanog nalaza.
Kako antibiotik „maskira“ infekciju
Bakterije mogu razviti različite mehanizme otpornosti, primjerice stvaranje enzima koji razgrađuju antibiotik ili promjene u staničnoj membrani koje otežavaju njegov ulazak. Kada se antibiotik uzme bez prethodne dijagnostike, može brzo ublažiti simptome, no to ne znači da je infekcija izliječena.
U mnogim slučajevima dolazi samo do smanjenja broja bakterija, dok one otpornije preživljavaju.
- Simptomi se privremeno povuku.
- Pacijent stekne dojam da je problem riješen i prekine terapiju prije vremena.
- Preživjele bakterije počinju novo razmnožavanje u izmijenjenom i otpornijem obliku.
Kada se simptomi vrate, infekcija bude teža, dugotrajnija i zahtijeva složeniji terapijski pristup.
Zašto je važno dati uzorak prije početka terapije
Jedna od najčešćih pogrešaka u liječenju infekcija je pogrešan redoslijed koraka. Antibiotik se često uzme odmah, dok se uzorak za analizu daje tek kasnije, kada simptomi ne prolaze. U tom trenutku nalaz često više ne pokazuje stvarnog uzročnika infekcije.
Tada je liječnik prisiljen donositi odluke na temelju pretpostavki, što može:
- Produžiti liječenje.
- Povećati mogućnost ponovnog javljanja simptoma.
- Uzrokovati nepotrebno uzimanje antibiotika za virusne infekcije (npr. kod upale grla).
Davanjem uzorka prije početka terapije omogućuje se precizno određivanje bakterije i odabir antibiotika koji doista djeluje.
Antibiogram kao zapis prethodnih terapija
Kada bakterije izrastu na hranjivoj podlozi, radi se antibiogram. Riječ je o standardiziranom testu kojim se određuje osjetljivost izolirane bakterije na odabrane antibiotike.
U laboratoriju uzorak postavljamo na agar-ploču, a oko njega raspoređujemo diskove natopljene antibioticima. Nakon 18 do 24 sata inkubacije na 37 °C, rezultati su vidljivi:
- Prozirne zone oko diska pokazuju da je antibiotik učinkovit.
- Prisutnost bakterija do samog diska znači da je bakterija razvila otpornost.
Primjer iz prakse: Pacijent s upalom mokraćnog sustava započeo je terapiju „iz ladice“. Antibiogram je naknadno pokazao da je bakterija otporna na uobičajeni lijek, ali osjetljiva na drugi, ciljani antibiotik. Zahvaljujući testu, terapija je prilagođena, a simptomi su se brže povukli.
Na slici se vidi standardna Petrijeva ploča s diskovima antibiotika. Prozirne zone oko diska pokazuju da je antibiotik učinkovit protiv bakterije, dok prisustvo bakterija sve do samog diska znači da je bakterija razvila otpornost.
Zašto „znam što mi pomaže“ često nije točno
Mnogi pacijenti misle da se iste infekcije stalno ponavljaju jer simptomi izgledaju isto. Međutim, uzročnik ne mora biti isti. Različite bakterije izazivaju slične tegobe, a ista bakterija može s vremenom promijeniti osjetljivost na lijekove.
U našoj regiji (Balkan) bilježi se zabrinjavajući porast rezistencije:
- Klebsiella pneumoniae: Otpornost na kombinacije cefalosporina, fluorokinolona i aminoglikozida porasla je s 44,9% (2019.) na 64,9%.
- Escherichia coli: Bilježi povećanu otpornost nakon pandemije COVID-19 zbog neopravdane uporabe antibiotika.
Sve to pokazuje koliko se rezistencija brzo širi, često brže nego što stižu nove terapije.
Male navike koje čuvaju učinkovitost antibiotika
Iako problem antibiotske rezistencije djeluje složeno i daleko od svakodnevnog života, rješenja zapravo počinju u vrlo osnovnim koracima liječenja:
- Pravilna dijagnostika prije početka liječenja. Prvi i najvažniji korak je pravilna dijagnostika prije početka liječenja. Antibiotik se ne bi trebao uvoditi bez prethodne procjene, a kada je indicirano, i mikrobiološke analize. Ako se uzorak prikupi prije početka terapije, može se točno odrediti uzročnik infekcije i odabrati antibiotik koji doista djeluje. Time se izbjegava nepotrebna primjena lijekova širokog spektra, skraćuje trajanje liječenja i smanjuje rizik razvoja otpornosti.
- Provedite terapiju do kraja. Jednako je važno provesti terapiju do kraja, točno onoliko dugo koliko je propisano. U većini slučajeva simptomi se povuku prije nego što je infekcija u potpunosti izliječena, što pacijenta navede na prerani prekid terapije. Međutim, upravo u toj fazi preživljavaju otpornije bakterije, koje kasnije mogu uzrokovati teže i dugotrajnije infekcije.
- Zaboravite na ostatke iz ladice. Važno je podsjetiti i na naviku čuvanja i korištenja ostataka antibiotika, jer oni nisu sigurno rješenje za nove simptome. Njihova primjena bez jasne indikacije može otežati pravilno liječenje i potaknuti razvoj novih, otpornijih sojeva.
- Antibiotici ne liječe virusne infekcije. Posebno ističem da antibioticima ne možemo liječiti virusne infekcije. Većina sezonskih respiratornih infekcija uzrokovana je virusima, na koje antibiotici ne djeluju. Njihova uporaba u tim situacijama ne ubrzava oporavak, nego povećava rizik širenja rezistencije.
Zaključak: odgovornost koja spašava živote
Antibiotici su jedno od najvećih dostignuća medicine, ali njihova moć nije beskonačna. Svaki put kada ih koristimo nepravilno, gubimo dio te moći. U eri sve veće rezistencije, laboratorijska dijagnostika nije opcija, nego jedini put prema sigurnom izlječenju. Sljedeći put, umjesto da posegnete za starim antibiotikom, odnesite uzorak na analizu i sačuvajte učinkovitost lijekova za buduće generacije.
Izvori:
- Filev, R., et al. (2025). From Pandemic to Resistance: Addressing Multidrug-Resistant Urinary Tract Infections in the Balkans. https://doi.org/10.3390/antibiotics14090849
- Kardas, P., et al. (2007). A global survey of antibiotic leftovers in the outpatient setting. https://doi.org/10.1016/j.ijantimicag.2007.08.005
- Jadhav, V. B., et al. (2025). Impact of Pre-Existing urinary antimicrobial agents on culture yield. https://doi.org/10.7759/cureus.84038
- Machowska, A., & Stålsby Lundborg, C. (2019). Drivers of Irrational Use of Antibiotics in Europe. https://doi.org/10.3390/ijerph16010027
O autorici: Asja Omerović studentica je genetike i bioinženjerstva, članica Udruženja „Zajedno zdraviji“, s iskustvom rada u mikrobiološkom laboratoriju i interesom za znanstvenu komunikaciju i javno zdravlje. Kontakt: asja.omerovic@outlook.com
Napomena: Fotografija Petrijeve zdjelice korištena u izvornom radu nastala je tijekom stručne prakse uz poštivanje etičkih standarda.
Imate prijedlog, ideju, prigovor ili ste uočili grešku? Javite nam se ovdje.



